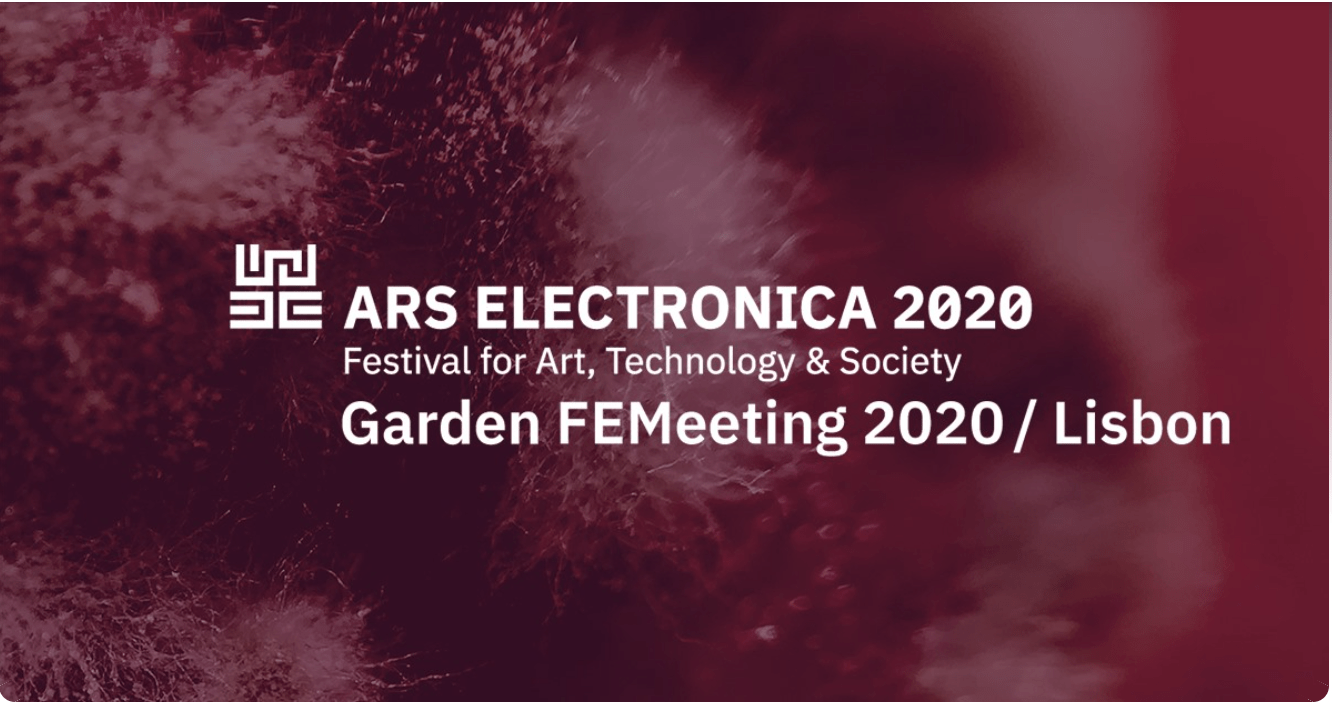

An additional conference space for the international community FEMeeting: Women in Art, Science and Technology has been created in MozillaHubs: FEMeeting 2020 Garden.
Inspired by the environment of the 2018 and 2019 conferences in Portugal and the structure of FEMeeting WEB 2020, the digital architecture of this new venue reflects the wide range of interests and experiences of the FEMeeting members.
Launched in 2017, “FEMeeting: Women in Art, Science and Technology” was driven by the desire to develop and promote more direct collaboration between individuals who identify themselves as Women, independently of their sex . The idea behind FEMeeting was orchestrated by the Portuguese artist Marta de Menezes and scholar Dalila Honorato, after realizing that women in the field of Art and Science have an unquestionable presence worldwide.
Among the project’s distinguishable objectives there are: (a) a strong personal support through instant internet communication between women doing research work (in the broadest sense of the term) in art, science and technology (b) and the encouragement towards the formation of local nodes to support research and artistic creation developed to enable a wide network of direct communication among them and encourage trust.
FEMeeting 2020 Garden presents the harvest of the works conducted by the international community “FEMeeting: Women in Art, Science and Technology” since its inception. FEMeeting aims to disseminate projects carried out by individuals who identify themselves as Women in order to contribute (a) to the development of research methodologies in art and science and (b) to the development of collaboration strategies that can increase knowledge sharing and bring communities together.
FEMeeting 2020 Garden is supported by Cultivamos Cultura.
Project Credits:
Marta de Menezes, Cultivamos Cultura, PT
Dalila Honorato, Ionian University, GR
Kathy High, NATURE Lab, a project of The Sanctuary of Independent Media, and Rensselaer Polytechnic Institute, Troy NY, US
Branda Miller, The Sanctuary for Independent Media and Rensselaer Polytechnic Institute, Troy NY, US
Annick Bureaud, Leonardo/OLATS, FR
Pavel Tavares, Cultivamos Cultura, PT
Claudia Figueiredo, Cultivamos Cultura, PT
Ricardo Guerreiro Campos, Cultivamos Cultura, PT
Diana Aires, Cultivamos Cultura, PT
Acknowledgements:
FEMeeting 2018 Scientific & artistic committee:
Maria Teresa Cruz, PT
Marta de Menezes, PT
Leonor Saúde, PT
Dalila Honorato, PT/GR
Shannon Bell, CA
Kathy High, US
María Antonia González Valério, MX
Ionat Zurr, AU
Jenifer Wightman, US
Organizing committee:
Marta de Menezes, PT
Dalila Honorato, PT/GR
Cultivamos Cultura Team:
Claudia Figueiredo, PT
Luis Graça, PT
Ricardo Guerreiro Campos, PT
Diana Aires, PT
Support:
Cultivamos Cultura, PT
Center for Research in Communication Information and Digital Culture, PT
Fundação Eugénio de Almeida, PT
Faculdade de Belas-Artes da Universidade de Lisboa, PT
Leonardo/ISAST, US
Municipio de Odemira, PT
Naturarte Turismo Rural, PT
Direção Geral de Cultura do Alentejo, PT
Fundaçãoo para a Ciência e Tecnologia, PT
FEMeeting 2019 Scientific & artistic committee:
Dalila Honorato, GR
Maria Manuela Lopes, PT
Victoria Vesna, US
Ionat Zurr, AU
Jenifer Wightman, US
Kathy High, US
Laura Beloff, DK
María Antonia González Valério, MX
Marta de Menezes, PT
Shannon Bell, CA
Organizing committee:
Marta de Menezes, PT
Dalila Honorato, PT/GR
Kathy High, US
Victoria Vesna, US
Laura Beloff, DK
Maria Antonia Gonzalez Valerio, MX
Maria Manuela Lopes, PT
Cultivamos Cultura Team:
Claudia Figueiredo, PT
Luis Gra.a, PT
Ricardo Guerreiro Campos, PT
Diana Aires, PT
Support:
Cultivamos Cultura, PT
Municipio de Odemira, PT
Naturarte Turismo Rural, PT
Direção Geral de Cultura do Alentejo, PT
Faculdade de Belas-Artes da Universidade de Lisboa, PT
Instituto de Investigação e Inovação em Saúde da Universidade do Porto, PT
FEMeeting WEB 2020
Antibodies Organizing committee:
Marta de Menezes PT
Dalila Honorato PT/GR
Kathy High, US
Branda Miller, US
Annick Bureaud, FR
Support:
FEMeeting, PT
Cultivamos Cultura, PT
Leonardo/OLATS, FR
The Sanctuary for Independent Media, US
NATURE Lab, a project by The Sanctuary for Independent Media, US
The Daniel and Nina Carasso Foundation FR
Rensselaer Polytechnic Institute, US
Ionian University GR
Cultivamos Cultura Team:
Claudia Figueiredo, PT
Luis Graça, PT
Ricardo Guerreiro Campos, PT
Diana Aires, PT
Leonardo/OLATS Team:
Ewen Chardronnet, FR
Susmita Mohanty, FR
Quentin Aurat, FR
Jean-Yves Leloup, FR
FEMeeting Participants:
Adriana Knouf, US
Agnes Chavez, US
Alan Tod, PT
Alex May, UK
Alison Powell, PT
Allison Berkoy, US
Allison Leigh Holt, US
Amy M. Youngs, US
Ana Baleia, PT
Ana Barroso, PT
Ana Santos, PT
Ana Teresa Vicente, PT
Anastasiia Melai, UA/DE
Andrea Gogov., SK
Angela Beallor, US
Anita McKeown, IR
Anna Dumitriu, UK
Anna Jakobsson, SE
Anna Lindemann , US
Anna Rewakowicz, PL/CA/FR
Anna-Isaak Ross, US
Annick Bureaud, FR
Aoife van Linden Tol, UK
Boryana Rossa, BG/US
Branda Miller, US
Carlos Ueira-Vieira, BR
Carolyn Angleton, US
Catarina Pombo Nabais, PT
Cathrine Kramer, NO
Cecilia Vilca, PE
Cesar Baio, BR
Charissa N. Terranova, US
Claire Nettleton, US
Clarissa Ribeiro, BR
Claudia Jacques, BR/US
Clio Flego, IT
Cosima Herter, CA
Cynthia White, USA
Dalila Honorato, PT/GR
Daniela de Paulis, NL
Danielle Siembieda, US
Dipali Gupta, SG
Dolores Steinman, CA
Domenica Mediati, CA
Ebru Yetiskin, TR
Elaine Whittaker, CA
Elizabeth Littlejohn, CA
Elizabeth Press, US
Elizaveta Glukhova, NL
Ellen K. Levy, US
Ellie Irons, US
Eugénie Eyeang, GA
Fabiane Borges, BR
Fabiola Fonseca, BR
Fara Peluso, DE
Félicie d’Estienne d’Orves, FR
Flis Holland, FI
Giulia Tomasello, UK
Hana van der Kolk, US
Hazelle Lerum, US
Hege Tapio, NO
Heidi-Annica Ljungqvist, FI
Helena Ferreira, PT
Helena Loermans, NL/PT
Héléne Ben Aém Drieux, FR
Hined Rafeh, US
Ionat Zurr, AU
Irena Paskali, DE
Isabel Burr-Raty, CL/BE
Itziar Zorita, ES
Jacqueline Simon, US
Jane Prophet, USA/UK
Jasna Jernejsek, SI
Jenifer Wightman, US
Jennifer Willet, CA
Jennifer Zackin, US
Jimena Garc.a .lvarez-Buylla, MX
Jo Wei, CN
Joan Linder, US
Joana Magalh.es, ES/PT
Jo.o Henrique Lodi Agreli, BR
Johanna Rotko, FI
Jude Abu Zaineh, CA/US
Julia Arimany, ES
Julia Bentz, AT/PT
Karolina Żyniewicz, PL
Katherine Behar, US
Kathleen McDermott, US
Kathleen Rogers, UK
Kathy High, US
Kira O’Reilly, IE/FI
Kitsou Dubois, FR
Kris Casey, US
Laura Beloff, FI/DK
Laura Benítez Valero, ES
Lena Ortega, MX
Lila Moore, UK
Lisa Cartwright, US
Lisa Thomas, US
Liz Lessner, USA/BR
Louise Mackenzie, UK
Lucile Olympe Haute, FR
Manuelle Freire, FR
Margaretha Haughwout, US
María Antonia González Valerio, MX
Maria Francisca Abreu Afonso, PT
Maria Manuela Lopes, PT
Maria Teresa Cruz, PT
Mariana Perez-Bobadilla, HK
Marie-Pier Boucher, CA
Mark Lipton, CA
Marne Lucas, US
Marta de Menezes, PT
Mary Maggic, USA/AT
Maya Fernandes Kempe, PT
Maya Minder, CH
Melanie King, UK
Merete Lie, NO
Michela Villani, CH
Michelle Hanlon, US
Michelle Lewis-King,CN
Michelle Sales, BR
Minerva Hernandez, MX
Minna L.ngstr.m, FI
Mirela Alistar, US
Miriam Simun, US
Mirjana Povic, ET
M.nica Mendes, PT
Monika Bakke, PL
Nancy D. Campbell, US
Nathalie Dubois Calero, CA
Neha Satak, IN
Nicole Clouston, CA
Nicole Condon- Shih, CN/US
Nina Czegledy, CA
Nina Sellars, AU
Nora Vaage, NL
Olga Majcen Linn, HR
Paula Pin, ES
Paulina Hubard, MX
Paz Tornero, ES
Pepa Ivanova, BE
Polona Tratnik, SI
Rachel Mayeri, US
Rebecca Cummins, US
Regine Rapp, DE
Renata Rosado Alves, BR/PT
Reno Almeida, BR
Roberta Buiani, CA
Rosanna Gunnarsson, SE
Ryder Cooley, US
Sanja Vodovnik, CA/SI
Sarah Blissett, UK
Sarah Hermanutz, CA/DE
Saša Spačal, SI
S.gol.ne Guinard, FR
Shannon Bell, CA
Stephanie Loveless, US
Stephanie Rothenberg, US
Sujata Majumdar, NL
Suncica Ostoic, HR
Susana Gómez Larraíaga, UK
Suzanne Thorpe, US
Tagny Duff, CA
Tamar Gordon, US
Tanha Gomes, CA
Tarsh Bates, AU
Teresa Almeida, DK
Vanessa Lorenzo Toquero, CH
Verena Friedrich, DE
Victoria Vesna, US
Vidhu Aggarwal, US
Yeon Kyoung Lim, HK
Yulia Akisheva, FR